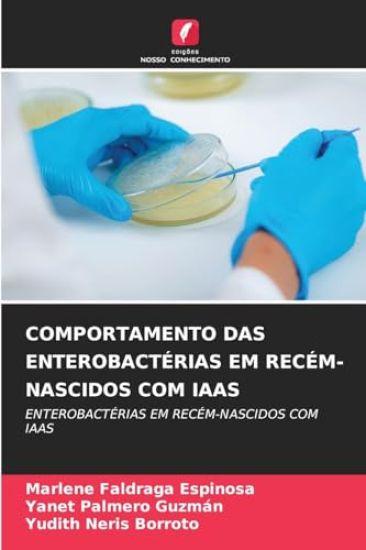
Comportamento Das Enterobactérias Em Recém-Nascidos Com Iaas

It is possible to be kind even when you feel sad or don't yet have everything you want.Showing kindness is not always easy, but everyone can do it.Use this book to teach your ch...
1000 tulosta hakusanalla Naris Palmer.

Comportamiento de las enterobacterias en neonatos con IAAS
Marlene Faldraga Espinosa; Yanet Palmero Guzmán; Yudith Neris Borroto · ISBN 9786208826628
Julkaistu 2025 Kieli espanja pokkari

Verhalten Von Enterobakterien Bei Neugeborenen Mit Iaas
Marlene Faldraga Espinosa; Yanet Palmero Guzmán; Yudith Neris Borroto · ISBN 9786208908539
Julkaistu 2025 Kieli saksa pokkari

Behavior of Enterobacteria in Neonates with Iaas
Marlene Faldraga Espinosa; Yanet Palmero Guzmán; Yudith Neris Borroto · ISBN 9786208908546
Julkaistu 2025 Kieli englanti pokkari

Comportement Des Entérobactéries Chez Les Nouveau-Nés Atteints d'Iaas
Marlene Faldraga Espinosa; Yanet Palmero Guzmán; Yudith Neris Borroto · ISBN 9786208908560
Julkaistu 2025 Kieli Ranska pokkari

Comportamento Degli Enterobatteri Nei Neonati Con Iaas
Marlene Faldraga Espinosa; Yanet Palmero Guzmán; Yudith Neris Borroto · ISBN 9786208908577
Julkaistu 2025 Kieli italia pokkari

Zachowanie Enterobakterii U Noworodków Z Iaas
Marlene Faldraga Espinosa; Yanet Palmero Guzmán; Yudith Neris Borroto · ISBN 9786208908584
Julkaistu 2025 Kieli puola pokkari
Comportamento Das Enterobactérias Em Recém-Nascidos Com Iaas
Marlene Faldraga Espinosa; Yanet Palmero Guzmán; Yudith Neris Borroto · ISBN 9786208908591
Julkaistu 2025 Kieli portugali pokkari

Naris istoriji serednovichnoji ta rannomodernoji Ukrajini
Natalja Jakovenko · ISBN 9786178631215
Julkaistu 2025 Kieli ukraina sidottu
Natalja Jakovenko - doktorka istorichnikh nauk, perekladachka, profesorka kafedri istoriji Kijevo-Mogiljanskoji akademiji, zasluzhena dijachka nauki i tekhniki Ukrajini. U 2006...

My Show-Off Wife Kiran: Exhibitionist Indian Wife
Naris Jaris; J. K. Gladstone · ISBN 9781547266517
Julkaistu 2017 Kieli englanti nidottu
"My show-off wife Kiran" is the story of a na ve Indian wife Kiran who even tried hard but couldn't obviate her past. She didn't know about her tendencies of an exhibitionist. B...

My Slut Wife Rekha: The Sex Adventures of My Gorgeous Indian Wife.
Naris Jaris; J. K. Gladstone · ISBN 9781547289165
Julkaistu 2017 Kieli englanti nidottu

My Demure Wife Tanvi: Exhibitionist Indian Wife
Naris Jaris; J. K. Gladstone · ISBN 9781548058968
Julkaistu 2017 Kieli englanti nidottu

My Desperate Wife Jaya: Exhibitionist Indian Wife
Naris Jaris; J. K. Gladstone · ISBN 9781548512507
Julkaistu 2017 Kieli englanti nidottu

Efficacy of Training and Development at a Higher Institution in Namibia
Sylvia N Naris; Wilfred I Ukpere · ISBN 9783838384146
Julkaistu 2011 Kieli englanti pokkari

Neris and India's Idiot-Proof Diet
India Knight; Neris Thomas · ISBN 9780141027432
Julkaistu 2008 Kieli englanti pokkari
India Knight and Neris Thomas's top top ten bestseller Neris and India's Idiot Proof Diet is a hilariously honest account of a low-carb diet that actually works.Ever wanted a di...

Neris and India's Idiot-Proof Diet Cookbook
Bee Rawlinson; India Knight; Neris Thomas · ISBN 9780141034867
Julkaistu 2009 Kieli englanti pokkari
In Neris and India's Idiot-Proof Diet Cookbook India Knight and Neris Thomas enlist the help of Bee Rawlinson to create over a hundred low-carb recipes to help you get 'from pig...
In the mountain of books that have been written about the Third Reich, surprisingly little has been said about the role played by the German nobility in the Nazis' rise to power...

Nazis in Skokie: Freedom, Community, and the First Amendment
Donald Alexander Downs · ISBN 9780268009687
Julkaistu 1985 Kieli englanti sidottu
In 1977, a Chicago-based Nazi group announced its plans to demonstrate in Skokie, Illinois, the home of hundreds of Holocaust survivors. The shocked survivor community rose in p...

Nazis, Islamists, and the Making of the Modern Middle East
Barry Rubin; Wolfgang G. Schwanitz · ISBN 9780300140903
Julkaistu 2014 Kieli englanti sidottu
A groundbreaking account of the Nazi-Islamist alliance that changed the course of World War II and influences the Arab world to this day During the 1930s and 1940s, a unique and...



